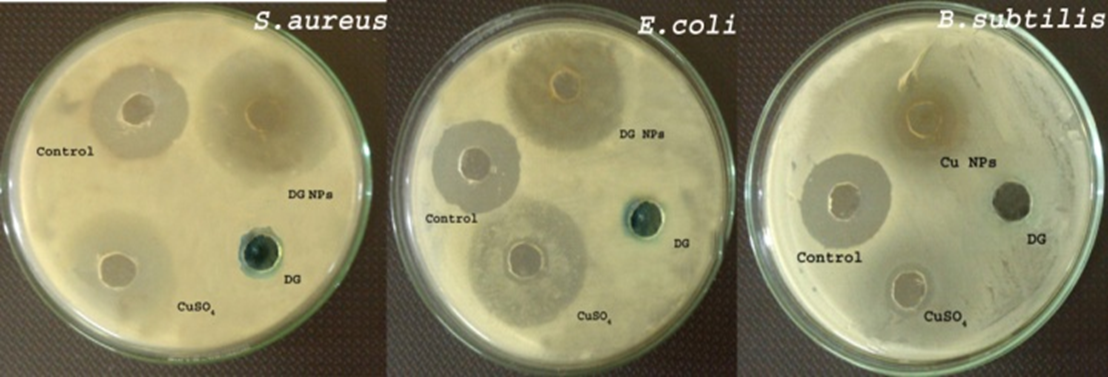

Int J Pharm Pharm Sci, Vol 7, Suppl 1, 60-65Original Article
SYNTHESIS OF COPPER OXIDE NANOPARTICLES USING DESMODIUM GANGETICUM AQUEOUS ROOT EXTRACT
ROHIT GUIN, SHAKILA BANU A, GINO A KURIAN*
School of Chemical and Biotechnology, SASTRA University, Thanjavur, Tamil Nadu
Email: ginokurian@hotmail.com
Received: 15 Nov 2014 Revised and Accepted: 16 Dec 2014
ABSTRACT
Objective: In this present work, we have synthesized Copper oxide nanoparticles using Desmodium gangeticum root extracts and explored its biological activity.
Methods: The Copper oxide nanoparticles were synthesized by the reduction process. Copper oxide nanoparticles were purified and dried. Scanning electron micrograph analysis showed evenly distributed Copper oxide nanoparticles and was confirmed by UV visible spectroscopy. Characterization of Copper oxide nanoparticles was done with Fourier Transform Infra-Red spectroscopy (FTIR) and Thermo Gravimetric Analysis (TGA). Gram negative and gram positive, bacteria were used to evaluate its antibacterial activity.
Results: Reducing potential and free radical scavenging ability of Copper oxide nanoparticles was measured and found to be high. Indeed, toxicological evaluation in LLC-PK1 cell line suggests that Copper oxide nanoparticles were safer for biomedical applications.
Conclusion: Biologically synthesized copper oxide nanoparticles show significant antioxidant effect and found to be less toxic as compared to the precursor thereby can be used as potential candidate species for various biomedical applications.
Keywords: Copper oxide nanoparticles, Desmodium gangeticum, Antioxidant, LLC-PK1 cell line.
INTRODUCTION
Nanotechnology is an emerging field nowadays attracted by many investigators and being targeted for its unparalleled programme. Modified metallic nanoparticles with various chemicals fabricated for conjugating antibodies, ligands, drugs, enable to have a wide range of uses in biological research and applications. Recently it has been used for therapeutic drug delivery and the treatments of various diseases and disorders, as well. Among the engineered nanoparticles, copper oxide nanoparticles play a significant role in different biological application.
Due to its unique optical [1], catalytic [2], mechanical and thermal [3] conduction properties copper oxide nanoparticles are widely used as compared to other metal nanoparticles. Chemical reduction [4-8], thermal decomposition [9], polyol [10, 11], laser ablation [12, 13], electron beam irradiation [14]are some of the widely used methods to synthesize copper nanoparticles. Due to the simplicity and economy, chemical reduction is the most preferred, but these methods do have limitations such as expensive, the generation of hazardous toxic chemicals. Hence need for further study to develop safe, eco-friendly alternative approaches in the synthesis of nanoparticles are warranted. Recently silver nanoparticles were synthesized using olive leaf extracts with good antibacterial activity [15].
In this manuscript, we focused on the green synthesis of copper nanoparticles using aqueous root extract of Desmodium gangeticum as it has potent reducing activity and also widely used as a drug [16]. Desmodium gangeticum is a small perennial herb belongs to Fabaceae family found in India, China, Africa and Australia. Desmodium gangeticum contains several flavonoid, glycosides, pterocarpenoids, lipids, glycolipid, amino glucosyl glycerolipid and alkaloids [17, 18]. It is an important plant used in the indigenous system of Indian Medicine of Ayurveda to treat various conditions such as snakebite, ulcer, ischemia reperfusion injury [19], myocardial infarction [20] and diabetes mellitus [21, 22] and also used as anti leishmanial [23], anti inflammatory [24] and as an cardio protective drug. The aqueous extract of plant root also contains hypo cholesterolemic and antioxidant activities as well.
The aim of the present study is to synthesize and characterize copper nanoparticles by using Desmodium gangeticum root extracts, followed by evaluating its biological activities like antimicrobial and antioxidant.
Experimental section
Materials and reagents
Copper sulfate (CuSO4) purchased from Sigma Aldrich, DPPH, nitro blue tetrazolium, riboflavin, hydrogen peroxide, sodium nitroprusside, Griess reagent, Folin-ciocalteu reagent, sodium carbonate and potassium hexacyano ferrate were purchased from Sigma Aldrich; Muller Hinton agar and Agar agar from HI-MEDIA; LLC-PK1 cell line (NCCS Pune, India) were used.
Methodology
Preparation of aqueous Desmodium gangeticum root extract
Desmodium gangeticum roots were collected from the botanical garden of St. Berchmann‘s college Kerala authenticated by HOD, Botany Department, SB college (voucher of the specimen was kept for reference). Dried roots were washed thoroughly with tap water and dried in the shade. Roots were cut into small pieces and ground coarsely using pulverizer. Soxhlet extraction was then performed to obtain crude aqueous extract, which is stored in the refrigerator for further use.
Synthesis of copper oxide nanoparticles
Copper oxide nanoparticles were synthesized using CuSO4 (10 mM) as the precursor and was then treated with aqueous DG root extract, it was in the ratio 1:4 and heated @ 80 oC. Color change from brown to black was used to confirm the formation of copper oxide nanoparticles. The obtained nanoparticles were dried and stored.
Characterization of copper oxide nanoparticles
UV-Visible spectroscopy
UV visible spectrophotometer was used to carry out the preliminary characterization of copper oxide nanoparticles to confirm its presence. UV spectral measurement was done in a range of wavelength between 300-800 nm.
Scanning electron microscopy
The size and morphology of copper oxide nanoparticles were studied using scanning electron microscopy (SEM-JEOL F-6400). The copper oxide nanoparticle powder was dissolved in a suitable solvent and a thin film is prepared on the carbon coated copper grid. Excess solvent was removed by blotting paper then allowed the sample to stand for 5 min. The SEM images were recorded at 40, 000 X magnification operating at 20 kV.
XRD analysis
X-ray diffraction (XRD) can be used to estimate the size of the particles and the crystalline structure. XRD gives a diffraction pattern of the sample and this was compared to the reference peak/pattern (JCPDS). XRD measurement of Copper oxide nanoparticles was carried out in a wide range of Bragg angles (θ) at a scanning rate of 2 °min−1, using RIGAKU instrument at an operating voltage of 40 kV and current of 30 mA with Cu-Kα radiation (1.5405 Å) as an x-ray source. The scanning has been done in the region of 2 hrs from 200 to 800 at 0.020/min, and the time constant was 2 seconds. Line broadening from the XRD pattern is used to calculate the crystal size using Debye Scherrer formula as given in equation I and this result was indeed be compared with SEM results.
Where, λ (lambda) is the wavelength of X-ray source (0.1541 nm), β is FWHM (full width at half maximum), θ is the diffraction angle and D is particle diameter size.
Fourier transform infrared spectroscopy
To determine the functional group present in the copper oxide nanoparticles FTIR analysis was performed. For FTIR analysis, the dried copper nanoparticles were ground with KBr pellet and analyzed on a Perkin Elmer FTIR system in a diffuse reflection mode, operating at a resolution of 4 cm-1. The spectrum was recorded in the range between 4000 and 400 cm-1.
Thermo gravimetric analysis
To determine the thermal stability of the synthesized copper oxide nanoparticles, Thermo gravimetric analysis (TGA) was carried out, and weight loss was recorded using SDT-Q600 model, TA instrument USA. Measurement was made under a nitrogen atmosphere at a heating rate 10 οC/min with the temperature ranging from 25 οC-1000 οC.
Biological evaluation
Free radical scavenging activity–DPPH assay
DPPH [1, 1-diphenyl-2-picrylhydrazyl], is a stable free radical with purple color, whose intensity was measured spectrophotometrically at 510 nm. Antioxidant reduces DPPH to 1, 1-diphenyl-2-picryl hydrazine, a colorless compound. DPPH assay was carried out according to Solver-Rivas et al. (2000) protocol, with a slight modification. 20 µl of synthesized copper oxide nanoparticle was taken and added to 0.5 ml of an ethanolic DPPH solution (0.3 mM) followed by the addition of 0.48 ml of ethanol. The mixture was kept undisturbed for 30 min incubation at room temperature in dark. After 30 min the absorbance was measured at 518 nm. The scavenging of DDPH was calculated as follows:
Where ODcontrol is the absorbance of the DPPH in ethanol, ODtest is the absorbance of the test compound along with DPPH [25, 26].
Total phenol determination
The Folin-Ciocalteu assay is used for the determination of total phenolic compounds. 1 ml of copper oxide nanoparticle (mg/ml) was taken and added to 1 ml of 1:10 diluted Folin-Ciocalteu reagent. The mixture was incubated at room temperature for 5 min. After incubation, 4 ml of 1M Na₂CO₃ was added and left undisturbed for 15 min. Later, the absorbance was measured at 765 nm. Ascorbic acid was used as a standard and assayed as that of the test sample with serially diluted concentration and the calibration curve was plot [26].
Reducing power assay
Reducing power of copper nanoparticles was determined by Oyaizu method (1986) [27]. 0.75 ml of copper oxide nanoparticle was taken and added to 0.75 ml of 0.2 M (pH 6.6) phosphate buffer, followed by the addition of 0.75 ml of 1% potassium hexacyanoferrate. The mixture was incubated at 50 °C in a water bath for 20 min. 0.7 ml of 10% TCA solution was added to the mixture to stop the reaction. The mixture was then centrifuged (1500 rpm) for 10 min and 1.5 ml of supernatant was taken. To this, a mixture of 1.5 ml of distilled water and 0.1 ml of 0.1% FeCl3 was added and allowed for 10 min incubation. The absorbance was measured at 700 nm.
Antimicrobial activity
Antimicrobial activity of copper oxide nanoparticles was determined using the agar well diffusion method (Murray et. al 1995). 25 ml of molten and cooled Muller Hinton agar was poured in sterilized Petri dishes. The plates were left overnight at room temperature to check for any contamination. All the bacterial test organisms were grown in Mueller Hinton broth for 24 hrs. 100 μl nutrient broth cultures of each bacterial organism were used to prepare bacterial lawns in petri dishes. Agar wells (8 mm) were made with the help of a sterilized stainless steel cork borer. The wells in each plate were loaded with 100 μl of synthesized copper nanoparticles, along with the precursor. The inoculated plates were incubated at 37 °C. Ciprofloxacin was used as a positive control while distilled water was used as a negative control. The plates were kept for incubation and observed for the zone of inhibition after 18 hours treatment [28].
Toxicology
LDH assay was used to measure the Cytotoxicity of copper oxide nanoparticles. Cells (LLC-PK1) were cultured in 96 well plates. After it had reached 80% confluency, copper oxide nanoparticles and its precursor were added separately and incubated for 24 hours. After incubation, 50 μl of culture medium from each well were collected and incubated with the reaction mixture containing NAD+, lactate and 0.2 M phosphate buffer (pH-7.4) with volume of 50 μl each. The LDH activity was then calculated as follows:
Where AT is the absorbance at time ‘T’ [29].
Statistical analysis
For biological evaluation assays like DPPH, total phenol content, the reducing power assay, LDH activity, data signify the means±S. D of three samples and are representative of three independent experiments. All statistical analysis was performed using Graph Pad prism 5.
RESULTS AND DISCUSSION
Characterization of Copper nanoparticles prepared by Desmodium gangeticum root extracts
Our major findings: i) Preparation of copper oxide nanoparticles of size 28 nm by Desmodium gangeticum root extracts and characterized the product through UV, XRD, FTIR, SEM and TGA ii) Copper oxide nanoparticles were found to have significant antimicrobial activity against Escherichia coli, Staphylococcus aureus and Bacillus subtilis with good antioxidant activity and iii) Toxicological evaluation of copper oxide nanoparticles in LLC-PK1 cell line suggests the non-toxic nature of copper oxide nanoparticles. According to Iravani (2011), nanoparticles synthesized by using plant and plant products seems to be more stable and faster in synthesis, suitable for large scale production. Using an aqueous extract of Desmodium gangeticum root extracts we prepared copper oxide nanoparticles by reducing copper sulfate substrate. The formation and stability of copper oxide nanoparticle were initially analyzed by UV-Visible spectroscopy.
Fig. 1A shows the absorption spectra of the reaction mixture containing copper sulfate (10 mm) and Desmodium gangeticum aqueous root extract (2.5 mg/ml). The absorption spectra at 415 nm suggest the formation of copper oxide nanoparticles. Gans modification of Mie theory predicts that the shift in the surface plasmon resonance occurs when the particles deviates from spherical geometry. The single sharp SPR band in the absorption spectra predicts the spherical nature of copper oxide nanoparticles and was confirmed by UV-Visible spectroscopy.

Fig. 1: Characterization of copper oxide nanoparticle by UV-Visible spectrum, X-Ray Diffractometry and Fourier Transform Infrared Spectroscopy
Fig. 1B shows the XRD spectrum of biosynthesized copper oxide nanoparticles. It clearly indicates the presence of two crystalline phases’ viz., monoclinic cupric oxide (CuO) and cubic cuprous oxide (Cu2O). The peaks observed in the spectrum with 2θ Braggs angles of 30.26o, 36.45o and 62.56o are indexed as (110), (111) and (220) planes that are in good agreement with those of powder Cu2O from the International Center of Diffraction Data card (JCPDS file no. 05-0667). Peaks at 31.6o, 39.2o, 46.23o, 49.7o, 53.3o, 60.97o and 68.3o are indexed as (110), (111), (-112), (-202), (020), (-113) and (113) planes that are in good agreement with the values of monoclinic cubic phase of CuO (JCPDS file no. 45-0937). Peak with 2θ = 74.18o matches to the JCPDS pattern of copper nanoparticles (file no. 04-0836). This confirms the presence of copper oxide nanoparticles with face centered cubic structure [30, 31]. The average diameter of the particle was calculated by using Scherrer formula (eqn I) and found to be 1.46 nm.
In order to understand the nature of capping agent and the presence of different functional groups responsible for the synthesis of mono dispersed copper oxide nanoparticles, FTIR measurement was carried out. The interaction between different chemical species and changes in the chemical environment of the sample was studied. The FTIR spectrum of copper oxide nanoparticles is shown in Fig.1C absorption is in the range of 400-4000 cm-1. The spectra show main frequency band 617 cm-1 corresponds to Copper oxide in Cu2O phase [32]. The respecting wave number in the spectrum may provide information about capping agent contributed by DG. The frequency band at 2928 cm-1 in DG IR spectra is shifted towards 2924 cm-1 and refers to alkyl C-H stretching present in copper oxide nanoparticles. The other frequencies observed at 3416 cm-1, 2924 cm-1, 2854 cm-1, 1634 cm-1, 1400 cm-1corresponds to H-O-H stretching H bonded alcohols and phenols, C-H alkyl stretching, C-H stretching, C-O stretching.
Fig.1D shows the FTIR results of DG extract. The spectra show frequency bands 3746 cm-1, 2928 cm-1, 1400 cm-1 and 1079 cm-1 which is also present in the IR spectra of copper oxide nanoparticles which confirm the presence of DG phyto-constituents in the nanoparticles surface that may act as the capping agent.
Fig.1E shows thermo gravimetric spectrum of DG synthesized copper oxide nanoparticles. From the spectra, we can identify the physicochemical interaction between copper oxide nanoparticles and phyto-compounds in DG. The existence of physicochemical moisture either in the form of physical adsorption or in the chemically bound hydroxyl group was determined.

Fig. 2: Scanning electron micrograph of copper oxide nanoparticles
DG extract was observed to have a linear weight loss till 700 οC. However, bound onto the copper oxide nanoparticle surface, DG exhibits a delayed decomposition. At 700 °C, DG extracts shows 65% weight loss while copper oxide nanoparticles showed a 40% weight loss. This weight loss may be due to the decomposition of organic compounds present in DG. The first phase of decomposition starts at 160 °C till 370 °C which results in a 30 % weight loss. This may be due to the presence of phytosterols such as stigmasterol, genistein [33] (3416 cm-1), gallic acid, phenyl ethylamine, caffeic acid [34] in DG extract, confirmed by LCMS and GCMS analysis (data not shown) [35]. The IR peaks of genistein and caffeic acid in the nanoparticles indicates the interaction of DG with nanoparticles. Contrary to DG extract copper oxide nanoparticles showed 10.14% and 11.67% weight loss at 620 and 740 respectively.
Fig. 2 shows the SEM micrograph of DG synthesized copper oxide nanoparticles and supports the crystalline nature. The morphology of the copper oxide nanoparticles was observed by scanning electron microscope JEOL F-6400. In SEM analysis, the synthesized copper oxide nanoparticles of spherical shape show less aggregation of particles with diameters ranging from 10 to 60 nm with an average size of 28 nm.
Antimicrobial activity of DG synthesized copper nanoparticles
Gram positive bacteria namely Bacillus subtilis (MTCC-2413), Staphylococcus aureus (E1 MTCC-3160) and Gram-negative bacteria Escherichia coli (MTCC-574) were used to study antibacterial activity of copper oxide nanoparticles. The results were compared with ciprofloxacin, the positive control. It had been shown that copper kills microbes by rupturing the membrane by direct interaction or even by weakening the cell by increasing the membrane permeability.
Fig. 3: Antibacterial assay of copper oxide nanoparticles
The Enhanced antimicrobial activity of CuO nanoparticles obtained in our study suggests the significance of nano size in mediating some of the biological activities as compared to its macro size. The results are shown in fig.3 and table: 1 where the zone of inhibition of copper oxide nanoparticles was significantly higher as compared to DG extract and copper sulfate with Gram positive bacteria. On the other hand, treated with Gram negative bacteria, the extent of inhibition was less compared to the precursor but significantly higher when compared to the DG extract.
Table 1: Zone of inhibition obtained by well diffusion method
| Strain | Zone of inhibition diameter(mm) |
|---|---|
| Positive control | |
| Escherichia coli (MTCC-574) | 24.072 |
| Bacillus subtilis (MTCC-2413) | 23.876 |
| Staphylococcus aureus E1 (MTCC-3160) isolate 3 | 23.6 |
Total phenol determination
Phenolic compounds are a diverse group of secondary metabolites known for its ubiquitous bioactivity and are universally present in higher plants. The Folin-Ciocalteu phenol reagent is commonly used to estimate the amount of phenolic compounds present in the extract. However, the assay has been shown nonspecific not only to polyphenols but to any of another substance that could be oxidized by the Folin reagent as reported by various researchers. The low correlation between total polyphenol contents and the antioxidant activity of copper oxide nanoparticles suggest that the antioxidant potential of copper oxide nanoparticles may be because of the presence of non-phenolic compounds to as well. The concentration of total phenolic compounds in DG was found to be 1.505 mg/g ascorbic acid whereas in copper oxide nanoparticles, it was found to be 0.20875 mg/g ascorbic acid (fig. 4A).

Fig. 4: Total phenolic assay and reducing power assay of copper oxide nanoparticles
Reducing power assay
Reducing power is one of the indexes to assess the antioxidant potential of any compound. The reducing power of copper sulfate (precursor) was low when compared to of DG extract. However, the copper oxide nanoparticles prepared from them showed significantly high reducing potential than its precursor (fig. 4B).
Antioxidant potential of DG synthesized copper oxide nanoparticles
Inhibiting the free radical production or scavenging those molecules will be one of the modality for the treatment of numerous diseases. In order to assess the antioxidant potential of copper oxide nanoparticles, we used DPPH assay.

Fig. 5: DPPH scavenging assay of copper oxide nanoparticles
DPPH assay
DPPH [1, 1-diphenyl-2-picryl hydrazyl] is a stable free radical by virtue of the delocalization of the spare electron over the molecule as a whole with purple color, the intensity of which is measured spectrophotometrically at 510 nm. Antioxidants reduce DPPH to 1, 1-diphenyl-2-picryl hydrazine, a colorless compound. Copper oxide nanoparticles showed a dose dependent scavenging of free radical that confirming its antioxidant nature. While DG extract showed 80% DPPH scavenging effect. On the other hand, copper sulfate shows less DPPH scavenging activity compared to copper oxide nanoparticles. Hence, the enhanced DPPH scavenging ability of copper oxide nanoparticles may be due to the presence of the phyto-compounds present in DG (fig. 5)
Toxicology
Cytotoxicity study was performed in LLC-PK1 epithelial cell lines using the LDH assay. The toxic effect of copper oxide nanoparticles was found to be less as compared to DG aqueous root extracts and the precursor (CuSO4), copper oxide nanoparticles. (fig. 6)

*Values are represent edas mean±SD, (n=3)
Fig. 6: Toxicological evaluation of copper oxide nanoparticles–LDH assay
CONCLUSION
In conclusion, the above results suggest that Desmodium gangeticum root extract can synthesize copper oxide nanoparticles in economical and eco-friendly manner. The XRD analysis confirms that copper nanoparticles are crystalline in nature with cubic structure and the average crystalline diameter was found to be 1.46 nm. Copper oxide nanoparticles were thermally stable and can act as good antibacterial agent. Biologically synthesized copper oxide nanoparticles show significant antioxidant effect and found to be less toxic as compared to the precursor and DG extract, thereby can be used as potential candidate species for various biomedical applications.
ACKNOWLEDGEMENT
The authors greatly acknowledge SASTRA University for financial assistance and laboratory facilities.
CONFLICT OF INTERESTS
Declared None
REFERENCES
- Ponce AA, Klabunde KJ. Chemical and catalytic activity of copper nanoparticles prepared via metal vapor synthesis. J Mol Catal A: Chem 2005;225:1-6.
- Huang Z, Cui F, Kang H, Chen J, Zhang X, Xia C. Highly dispersed silica-supported copper nanoparticles prepared by precipitation−gel method: a simple but efficient and stable catalyst for glycerol hydrogenolysis. Chem Mater 2008;20:5090-9.
- Dang TMD, Le TTT, Fribourg-Blanc E, Dang MC. Synthesis and optical properties of copper nanoparticles prepared by a chemical reduction method. Adv Nat Sci: Nanosci Nanotech 2011;2:15009.
- Cheng X, Zhang X, Yin H, Wang A, Xu Y. Modifier effects on chemical reduction synthesis of nanostructured copper. Appl Surf Sci 2006;253:2727-32.
- Wu C, Mosher BP, Zeng T. One-step green route to narrowly dispersed copper nanocrystals. J Nanopart Res 2006;8:965-9.
- Yu W, Xie H, Chen L, Li Y, Zhang C. Synthesis and characterization of monodispersed copper colloids in polar solvents. Nanoscale Res Lett 2009;4:465-70.
- Zhang HX, Siegert U, Liu R, Cai WB. Facile fabrication of ultrafine copper nanoparticles in organic solvent. Nanoscale Res Lett 2009;4:705-8.
- Zhang X, Yin H, Cheng X, Hu H, Yu Q, Wang A. Effects of various polyoxyethylene sorbitan monooils (Tweens) and sodium dodecyl sulfate on reflux synthesis of copper nanoparticles. Mater Res Bull 2006;41:2041-8.
- Salavati-Niasari M, Fereshteh Z, Davar F. Synthesis of oleylamine capped copper nanocrystals via thermal reduction of a new precursor. Polyhedron 2009;28:126-30.
- Woo K, Kim D, Kim JS, Lim S, Moon J. Ink-Jet printing of cu−ag-based highly conductive tracks on a transparent substrate. Langmuir 2008;25:429-33.
- Park BK, Kim D, Jeong S, Moon J, Kim JS. Direct writing of copper conductive patterns by ink-jet printing. Thin Solid Films 2007;515:7706-11.
- Tilaki R, Mahdavi S. Size, composition and optical properties of copper nanoparticles prepared by laser ablation in liquids. Appl Phys A 2007;88:415-9.
- Zhang ZL, Jameson R, Zhao HW, Liu Y, Zhang SH, Zhang C. Beam dynamics design of an RFQ for a planned accelerator, which uses a direct plasma injection scheme. Nucl Instrum Methods Phys Res Sect A 2008;592:197-200.
- Mallick K, Witcomb MJ, Scurrell MS. In situ synthesis of copper nanoparticles and poly o-toluidine: A metal–polymer composite material. Eur Polym J 2006;42:670-5.
- Khalil MM, Ismail EH, El-Baghdady KZ, Mohamed D. Green synthesis of silver nanoparticles using olive leaf extract and its antibacterial activity. Arabian J Chem 2013;1878-5352.
- Kurian GA, Suryanarayanan S, Raman A, Padikkala J. Antioxidant effects of ethyl acetate extract of Desmodium gangeticum root on myocardial ischemia reperfusion injury in rat hearts. Chin Med 2010;5:3.
- Avasthi B, Tewari J. A preliminary phytochemical investigation of Desmodium gangeticum DC. J Am Pharm Assoc 1955;44:625-7.
- Mishra PK, Singh N, Ahmad G, Dube A, Maurya R. Glycolipids and other constituents from Desmodium gangeticum with antileishmanial and immunomodulatory activities. Bioorg Med Chem Lett 2005;15:4543-6.
- Kurian GA, Yagnesh N, Kishan RS, Paddikkala J. Methanol extract of Desmodium gangeticum roots preserves mitochondrial respiratory enzymes, protecting rat heart against oxidative stress induced by reperfusion injury. J Pharm Pharmacol 2008;60:523-30.
- Kurian GA, Philip S, Varghese T. Effect of aqueous extract of the Desmodium gangeticum DC root in the severity of myocardial infarction. J Ethnopharmacol 2005;97:457-61.
- Ghosal S, Bhattacharya SK. Desmodium alkaloids II. Chemical and pharmacological evaluation of D. gangeticum. Planta Med 1972;22:434-40.
- Ghosh D, Anandakumar A. Anti-inflammatory and analgesic activities of gangetin–A pterocarpenoid from Desmodium gangeticum. Indian J Pharmacol 1983;15:391.
- Singh N, Mishra PK, Kapil A, Arya KR, Maurya R, Dube A. Efficacy of Desmodium gangeticum extract and its fractions against experimental visceral leishmaniasis. J Ethnopharmacol 2005;98:83-8.
- Rathi A, Rao CV, Ravishankar B, De S, Mehrotra S. Anti-inflammatory and anti-nociceptive activity of the water decoction Desmodium gangeticum. J Ethnopharmacol 2004;95:259-63.
- Garcia EJ, Oldoni T, Alencar SMD, Reis A, Loguercio AD, Grande R. Antioxidant activity by DPPH assay of potential solutions to be applied on bleached teeth. Braz Dent J 2012;23:22-7.
- Patel A, Patel A, Patel N. Determination of polyphenols and free radical scavenging activity of Tephrosia purpurea linn leaves (Leguminosae). Phcog Res 2010;2:152.
- Pise N, Jena K, Maharana D, Gaikwad D, Jagtap T. Free radical scavenging, reducing power, phenolic and biochemical composition of Porphyra species. J Algal Biomass Util 2010;1:29-42.
- Valgas C, Souza SMD, Smânia EF, Smânia Jr A. Screening methods to determine antibacterial activity of natural products. Braz J Microbiol 2007;38:369-80.
- Prabhu BM, Ali SF, Murdock RC, Hussain SM, Srivatsan M. Copper nanoparticles exert size and concentration dependent toxicity on somatosensory neurons of rat. Nanotoxicol 2010;4:150-60.
- Nath S, Chakdar D, Gope G, Avasthi D. Characterization of CdS and ZnS quantum dots prepared via a chemical method on SBR latex. Nanotechnol 2008;4:1-6.
- Theivasanthi T, Alagar M. X-ray diffraction studies of copper nanopowder. Arch Phys Res 2010;1(2):112-7.
- Swarnkar R, Singh S, Gopal R. Effect of aging on copper nanoparticles synthesized by pulsed laser ablation in water: structural and optical characterizations. B Mater Sci 2011;34:1363-9.
- Pandit N, Patravale V. Design and optimization of a novel method for extraction of genistein. Indian J Pharm Sci 2011;73:184.
- Govindarajan R, Vijayakumar M, Shirwaikar A, Rawat AKS, Mehrotra S, Pushpangadan P. Antioxidant activity of Desmodium gangeticum and its phenolics in arthritic rats. Acta Pharm 2006;56:489.
- Kurian GA, Shabi M, Paddikkala J. Cardiotonic and anti ischemic reperfusion injury effect of Desmodium gangeticum root methanol extract. Turk J Biochem 2010;35:83-90.